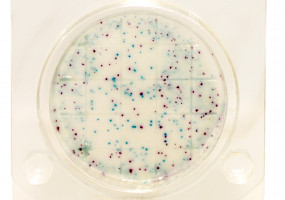
НПО Альтернатива
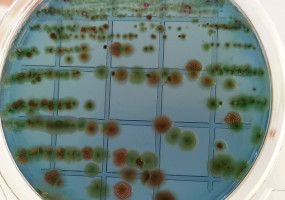
НПО Альтернатива

НПО Альтернатива
НПО Альтернатива разработчик и производитель уникальных решений для предприятий пищевой и перерабатывающей промышленности.
В линейке продуктов НПО Альтернатива представлены 4 направления:
- Униконс - комплексные пищевые добавки нового поколения, значительно увеличивающие сроки годности продуктов пищевой и сельскохозяйственной промышленности обеспечивает микробиологическую безопасность. Гарантируют отсутствие привкуса окислившегося жира, а также позволяют сохранить все высокие органолептические показатели в течение всего срока хранения.
- Микробиологические экспресс тесты «Петритест» российский аналог таких тест-систем, как Дипслайд, Petrifilm, RIDA COUNT, Oxoid, Orion Diagnostica, Schülke & Mayr, Merck Millipore, Singlepath, Duopath, MVP ICON, HY-RiSE, Envirocheck Dip Slides, MC-Media Pads , Sampler, HYCON Contact SlidesQuant
- По своему функционалу, стоимости и удобству применения Петритест заметно выделяется среди известных зарубежных производителей.
- АльтерСтарт - Стартовые культуры и Культуры плесени. Для производителей мясной и молочной продукции.
- Септоцил - антисептики и моющие средства.
Продукция по классификатору
Реквизиты
| ИНН | 6455055692 |
| Название юридического лица | НПО Альтернатива |
Контакты
 Адрес Адрес |
Саратов, Шелковичная, 186 оф 511 |
 Телефоны Телефоны |
|
 Почта Почта |
|
 Сайт Сайт |
|
 Вконтакте Вконтакте |
|
 YouTube YouTube |
Расположение на карте
НПО Альтернатива
Саратов, Шелковичная, 186 оф 511
Дата размещения/обновления информации: 26.02.2026г.
 Сообщить об ошибке
Сообщить об ошибке
Оставить отзыв
Похожие компании
Торговый Дом «Униконс» является эксклюзивным дистрибьютором продукции научно-производственное объединение «Альтернатива» (г. Саратов). Основной вид деятельности НПО - разработка и продвижение комплексных пищевых добавок, консервантов и антисептиков. Препараты «Альтернативы» успешно борются с широким спектром патогенных микроорганизмов - основной причиной порчи пищевой продукции.

Саратовский птицекомбинат «Курников» основан в 2002 году и в настоящий момент занимает лидирующее место среди производителей в сегменте глубокой переработки мяса птицы в России.
Компания «Славянские поля» — производитель и оптовый поставщик саратовских овощей.

ООО «Саратов-Холод Плюс» - крупная производственно-торговая компания. На сегодняшний день в продуктовый портфель собственного производства компании входят более 100 наименований мороженого, 80 позиций замороженных полуфабрикатов, овощей, грибов, ягод, овощных смесей.

Саратовская макаронная фабрика – крупнейшая фабрика среди 500 предприятий пищевой и перерабатывающей промышленности Саратовской области и одна из старейших фабрик России, перешагнувшая в 2008 году свой столетний юбилей.